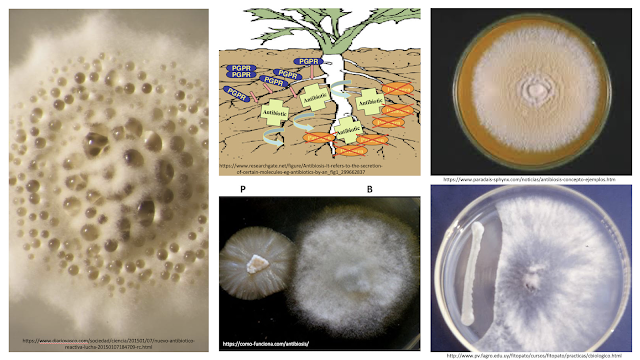

Relaciones interespecíficas
Relaciones interespecíficas
Responde a la interacción ecológica entre diferentes especies en una comunidad ecológica, a través de la perdida o ganancia para los individuos involucrados en la relación.
Utiliza simbología para representar la relación:
- Positivo (+): Indica que uno o ambos individuos se benefician y no hay daño.
- Negativo (-): Indica que hay un daño para uno o ambos individuos en la relación
- Cero (0): Establece que ninguno de los dos se beneficia, ni perjudica.
Relación (+)/(+)
Mutualismo
Interacción donde ambas especies se benefician
![]() |
| Picabotas (aves) vs Cebra Las aves obtienen comida y la cebra obtiene el control de la plaga (parásitos) https://www.pinceladasdelanaturaleza.es/2014/10/picabueyes-desparasitador-o-parasito.html |
Según los beneficios la relación de mutualismo se clasifica en:
- Recurso - recurso: ambos organismo obtienen beneficios tangibles (alimento o nutrientes)
- Recurso - servicio: un organismo obtiene un beneficio tangible (alimento o nutrientes) y el otro es intangible (hospedaje, limpieza, transporte, soporte, protección)
- Servicio - servicio: ambos organismos obtienen beneficios intangibles (hospedaje, limpieza, transporte, soporte, protección)
Otros ejemplos .....
Simbiosis
Se comporta igual que el mutualismo, donde ambos organismos se benefician, sin embargo la relación es más compleja ya que los organismo no pueden vivir sin la presencia del otro organismo.
Es considerada una relación obligada!!!!
Otros ejemplos de simbiosis ....
Relación (+)/(0)
Interacción en la cual uno de los dos organismo se beneficia y el otro ni se perjudica ni se beneficia.
![]() |
| Tiburón y pez rémora. El pez acompaña al tiburón y se beneficia al alimentarse de los restos de comida dejados por el tiburón, mientras que el tiburón no es perjudicado pero tampoco beneficiado. psu-biologia-que-es-el-comensalismo |
Tipos de comensalismo
Inquilinismo
Su relación radica en donde una de la especies busque única y exclusivamente, guarecerse, cobijo o protección en restos o hábitat de otras especies.
Tanatocresis (metabiosis)
Es una relación indirecta dado a que una de las especies ocupa o se apropia de alguna parte de otra especie, ya se por que esa especie no lo necesita, la expulsó o simplemente murió.
Otros ejemplos ....
Relación en la cual el beneficio lo recibe una de las especies al transportarse en otra. El beneficio no solo puede ser de traslado también puede ser para conseguir alimento.
Relación en la cual un organismos sésil o inmóvil (epibionte) se adhiere al tegumento de otro organismo (basibionte). La relación sirve para vivir o transportarse sobre el organismo sin afectarlo.
Relación (0)/(-)
Amensalismo
Interacción entre seres vivos, donde el antagonista inhibe o perjudica el desarrollo de otro sin obtener beneficio a cambio.
Antibiosis
En dicha relación una de las especies produce sustancias tóxicas o nocivas (antibióticos) que limitan el desarrollo de otra especie o la erradica.
Relación (+)/(-)
La relación se lleva a cabo donde un organismo se perjudica (presa) mientras que el otro se beneficia (depredador). Esta relación se lleva acabo entre animales carnívoros, insectívoros y omnívoros.
- Granívoros
- Folívoros
- Xilófagos
- Omnívoros
Parasitismo
Relación en la cual un organismos se ve perjudicado (hospedero) y el otro se ve beneficiado (parásito), es decir la especie parasitaria vive a expensas de su anfitrión.
El organismo parasitario puede ser:
- Endoparásito: dentro del organismo hospedero
- Ectoparásito: Fuera del organismo hospedero